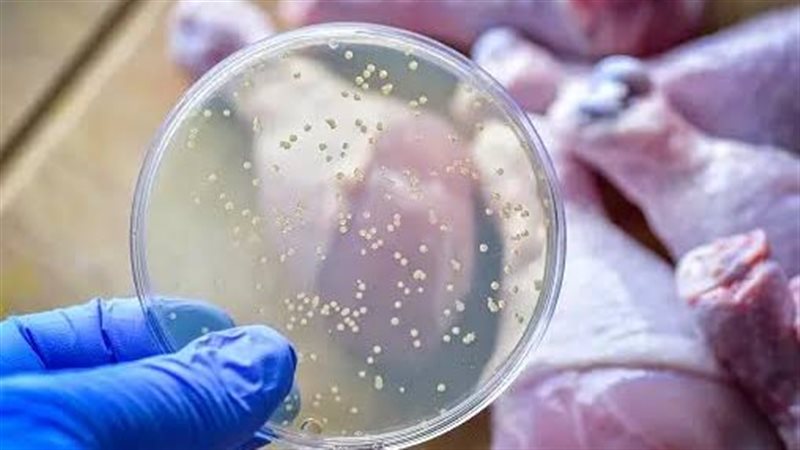
السالمونيلا

تحذير صحي في بريطانيا.. ارتفاع التسمم الغذائي بسبب السالمونيلا والسلطات الجاهز
السالمونيلا تعود إلى الواجهة من جديد في بريطانيا بعد تسجيل ارتفاع «مقلق» في عدد حالات التسمم الغذائي المرتبطة باستهلاك «السلطات الجاهزة» ومنتجات غذائية أخرى تحتوي على مكونات طازجة أو محفوظة، حيث أصدرت السلطات الصحية البريطانية تحذيرًا عاجلًا لجميع المواطنين بضرورة توخي الحذر من بعض المنتجات المنتشرة في الأسواق والتي قد تحتوي على بكتيريا السالمونيلا، وذلك في ظل موجة من التسممات التي اجتاحت عدة مناطق في البلاد خلال الأسابيع الأخيرة.
تحقيقات صحية موسعة
بدأت الهيئات الصحية في بريطانيا، وعلى رأسها وكالة الأمن الصحي البريطانية UKHSA، سلسلة من التحقيقات في أعقاب ارتفاع ملحوظ في الحالات التي نقلت إلى المستشفيات بسبب أعراض تتطابق مع أعراض الإصابة ببكتيريا السالمونيلا، حيث تضمنت الأعراض الشائعة «القيء المستمر» و«الإسهال الحاد» و«ارتفاع درجات الحرارة» و«آلام المعدة الشديدة»، وقد تم الربط بين تلك الحالات وبين استهلاك بعض أنواع «السلطات الجاهزة» المتوفرة في المتاجر الكبرى.
وقد كشفت التحاليل المبدئية التي أجريت على العينات الغذائية المشتبه بها عن وجود السالمونيلا في بعض العبوات، خاصة تلك التي تحتوي على مزيج من الدجاج والخضروات أو التونة والمايونيز، كما لم تستبعد الجهات المعنية أن يكون «سوء التخزين» أو «سلاسل التوريد» سببًا في تفشي هذه البكتيريا التي تعد من أخطر مسببات التسمم الغذائي في العالم.

أسباب محتملة ومصادر الخطر
من المعروف أن السالمونيلا تنتقل غالبًا من خلال تناول الأطعمة غير المطهية جيدًا أو الملوثة خلال عمليات التحضير أو التغليف، وقد يكون التلوث ناتجًا عن مصدر واحد مثل مصنع تعبئة أو مورد خضروات غير ملتزم بمعايير السلامة، لذلك فإن التحقيقات لا تزال مستمرة لتحديد «نقطة البداية» التي تسببت في انتشار هذه البكتيريا الخطيرة بين مئات المستهلكين في أنحاء بريطانيا.
وأشار عدد من مسؤولي الصحة العامة إلى أن السلطات تتابع عدة علامات تجارية كبرى، كما جرى بالفعل سحب بعض المنتجات من الأسواق كإجراء احترازي، فيما طُلب من المواطنين التحقق من تواريخ الإنتاج والانتهاء المدونة على عبوات السلطات الجاهزة والتوقف عن تناول أي منتج يشتبه في سلامته.
الفئات الأكثر عرضة للإصابة
تُعد بعض الفئات أكثر عرضة للتأثر ببكتيريا السالمونيلا مثل «الأطفال» و«كبار السن» و«النساء الحوامل» و«الأشخاص الذين يعانون من ضعف الجهاز المناعي»، ولهذا شددت التوصيات الطبية على ضرورة مراجعة الطبيب فورًا عند ظهور أي من أعراض التسمم الغذائي، خاصة إذا استمرت الأعراض لأكثر من يومين أو ظهرت علامات «الجفاف» و«الضعف العام».
وفي الوقت نفسه تم التنبيه على ضرورة غسل الأيدي جيدًا قبل وبعد تحضير الطعام، والحفاظ على درجة حرارة التبريد المطلوبة، وعدم ترك السلطات أو اللحوم المطهية خارج الثلاجة لفترات طويلة، وهي ممارسات تساهم بشكل مباشر في تقليل فرص انتقال السالمونيلا إلى المستهلكين.
إرشادات الوقاية والسلامة الغذائية
من بين النصائح التي قدمتها الجهات المعنية لتجنب السالمونيلا، عدم تناول الأطعمة التي يُشك في طزاجتها، والتأكد من أن اللحوم والدواجن والأسماك قد طُهيت بشكل جيد حتى الوصول إلى درجات حرارة كافية للقضاء على البكتيريا، بالإضافة إلى الالتزام باستخدام أدوات نظيفة خلال الطهي والتغليف.
كما أوصت بعدم شراء المنتجات المخفضة التي اقترب تاريخ صلاحيتها من الانتهاء، خاصة إن كانت من المنتجات التي تحتاج إلى حفظ دقيق مثل «السلطات» و«اللحوم الباردة» و«منتجات الألبان»، لأن هذه الفئة من الأغذية تعتبر بيئة مناسبة لنمو السالمونيلا في حال تعرضها لأي خلل في التخزين.
السلطات الجاهزة في دائرة الشك
السلطات الجاهزة باتت محور الحديث في وسائل الإعلام البريطانية بعد أن تبين أنها من أبرز مصادر التلوث في هذه الحملة، ويرى بعض الخبراء أن الإقبال المتزايد على هذه الأطعمة في فصل الصيف، بسبب ارتفاع درجات الحرارة ورغبة الكثيرين في تناول وجبات خفيفة وسريعة، ساهم في تفاقم المشكلة.
كما أن بعض المطاعم ومتاجر الأغذية لا تلتزم دومًا بأعلى معايير النظافة والتبريد، وهو ما يفتح المجال لانتقال السالمونيلا عبر المكونات الطازجة مثل الخس والطماطم والدجاج المبرد، خاصة إن لم يتم غسلها أو حفظها بالطريقة الصحيحة.
دعوة للمستهلكين والموردين
دعت الحكومة البريطانية جميع الموردين إلى مراجعة سلاسل التوريد الخاصة بهم، وإجراء فحوصات دقيقة على المنتجات التي يتم توريدها إلى الأسواق، كما طالبت المستهلكين بإبلاغ الجهات الصحية فورًا في حال ظهور أي أعراض مشتبه بها بعد تناول السلطات أو الأطعمة المحفوظة، وذلك لضمان تتبع مصادر التلوث بشكل فعال وسريع.
وأكدت الجهات الرسمية أنها لا تزال تتابع الوضع عن كثب، وأن هناك احتمالًا بتوسيع نطاق سحب المنتجات إذا ثبت تلوث دفعات جديدة من المواد الغذائية، فيما تم فتح خطوط ساخنة للتواصل مع المستهلكين وتلقي البلاغات الصحية.
تحذيرات مستقبلية وإجراءات وقائية
يشير تكرار ظهور السالمونيلا في الأسواق إلى وجود «ثغرات خطيرة» في منظومة سلامة الغذاء، ما يتطلب تكثيف حملات التفتيش والتوعية، ومحاسبة كل جهة تثبت مسؤوليتها عن أي إهمال يهدد صحة المواطنين، كما من المنتظر أن تصدر الجهات الصحية تحديثًا قريبًا حول قائمة المنتجات المتأثرة بهذه الأزمة، إلى جانب توصيات محدثة بخصوص «السلوك الغذائي الآمن» في ظل تزايد حالات التسمم.
ويظل الوعي الفردي هو السلاح الأول في مواجهة السالمونيلا، من خلال اتباع العادات الغذائية الصحيحة، ومراقبة المنتجات المستهلكة، ورفع مستوى الحذر تجاه كل ما يتعلق بتناول السلطات الجاهزة في هذه الفترة الحرجة.

